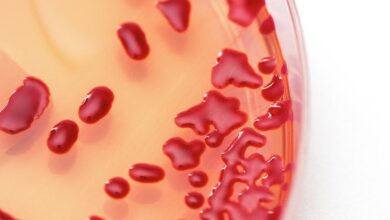

ροζ απόχρωση
- ΤΕΛΕΥΤΑΙΑ ΝΕΑ

Θαυμαστοβάκιλος: Τι είναι και πόσο επικίνδυνος είναι για την υγεία;
Ο θαυμαστοβάκιλος, γνωστός και ως Serratia marcescens, είναι ένα βακτήριο που συνήθως εμφανίζεται ως μια ροζ ή κοκκινωπή λάσπη σε…
Read More »
Ο θαυμαστοβάκιλος, γνωστός και ως Serratia marcescens, είναι ένα βακτήριο που συνήθως εμφανίζεται ως μια ροζ ή κοκκινωπή λάσπη σε…
Read More »Αγαπητέ/ή αναγνώστη/τρια,
Καταλαβαίνουμε απόλυτα ότι κανείς δεν θέλει ενοχλητικές διαφημίσεις. Ωστόσο, το Panictimes.gr βασίζεται αποκλειστικά στις διαφημίσεις για να παραμένει δωρεάν και προσβάσιμο σε όλους.
Με το AdBlock ενεργοποιημένο, μας στερείς τη μοναδική πηγή εσόδων που μας επιτρέπει να δημιουργούμε ποιοτικό περιεχόμενο καθημερινά.
Σε παρακαλούμε: ✅ Απενεργοποίησε το AdBlock για το Panictimes.gr ✅ Ή whitelist μας στις ρυθμίσεις του AdBlock.
Ακόμα και 10 δευτερόλεπτα με ορατές διαφημίσεις βοηθούν πολύ! 🙏
Ευχαριστούμε που μας στηρίζεις!